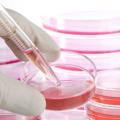
Νέα πιο αποτελεσματική μέθοδος δημιουργίας βλαστικών κυττάρων

Φέτος ο πολιτιστικός σύλλογος Κρουσώνα
«ΝΕΑ ΓΕΝΙΑ» σας προσκαλεί στη 2η γιορτή
Μήλου που διοργανώνει την Κυριακή...
Η καινοτομία φοιτητών που αναμένεται να κάνει θραύση Το Yerka είναι ένα ποδήλατο που δεν κλέβεται εύκολα. Οι επίδοξοι...
Πριν από έναν αιώνα, το φορητό τηλέφωνο υπήρχε μόνο στο μέτωπο και το χρησιμοποιούσαν οι στρατιώτες. Σήμερα, σχεδόν...
Οι μηχανικοί Jos Weyers και Christian Holler χρησιμοποιούν την τεχνολογία εκτύπωσης 3D για να παράγουν κλείδια, ικανά να...
Έρχεται το νέο κινητό iPhone 6 της Apple και παράλληλα έχει ήδη κυκλοφορήσει και το καινούργιο λογισμικό iOS8 το οποίο...
Τις εγκαταστάσεις του ελληνικού διαστημικού συνεργατικού σχηματισμού si-Cluster στο Μαρούσι επισκέφτηκαν εκπρόσωποι...
Την Παρασκευή 24 Οκτωβρίου θα ξεκινήσει η διάθεση των νέων iPhones στην ελληνική αγορα. Σύμφωνα με νεότερες πληροφορίες,...
Επιστήμονες στις ΗΠΑ, μεταξύ των οποίων ένας Έλληνας, ανακάλυψαν μια νέα πιο αξιόπιστη και αποδοτική τεχνική, που...
Μια ακόμη χρονιά, 24η στη σειρά, απονεμήθηκαν φέτος τα Βραβεία Ig, τα λεγόμενα και «Νόμπελ του τρελού επιστήμονα», τα...
Αμερικανοί επιστήμονες ανακάλυψαν έναν νευροχημικό μηχανισμό ελέγχου σε μια περιοχή του εγκεφάλου, που επεξεργάζετ
Το αρχαίο θέατρο βρίσκεται στη νότια επαρχία των Αδάνων, ενώ η Μάγαρσος είναι μια από τις Ελληνικές πόλεις που δεν...